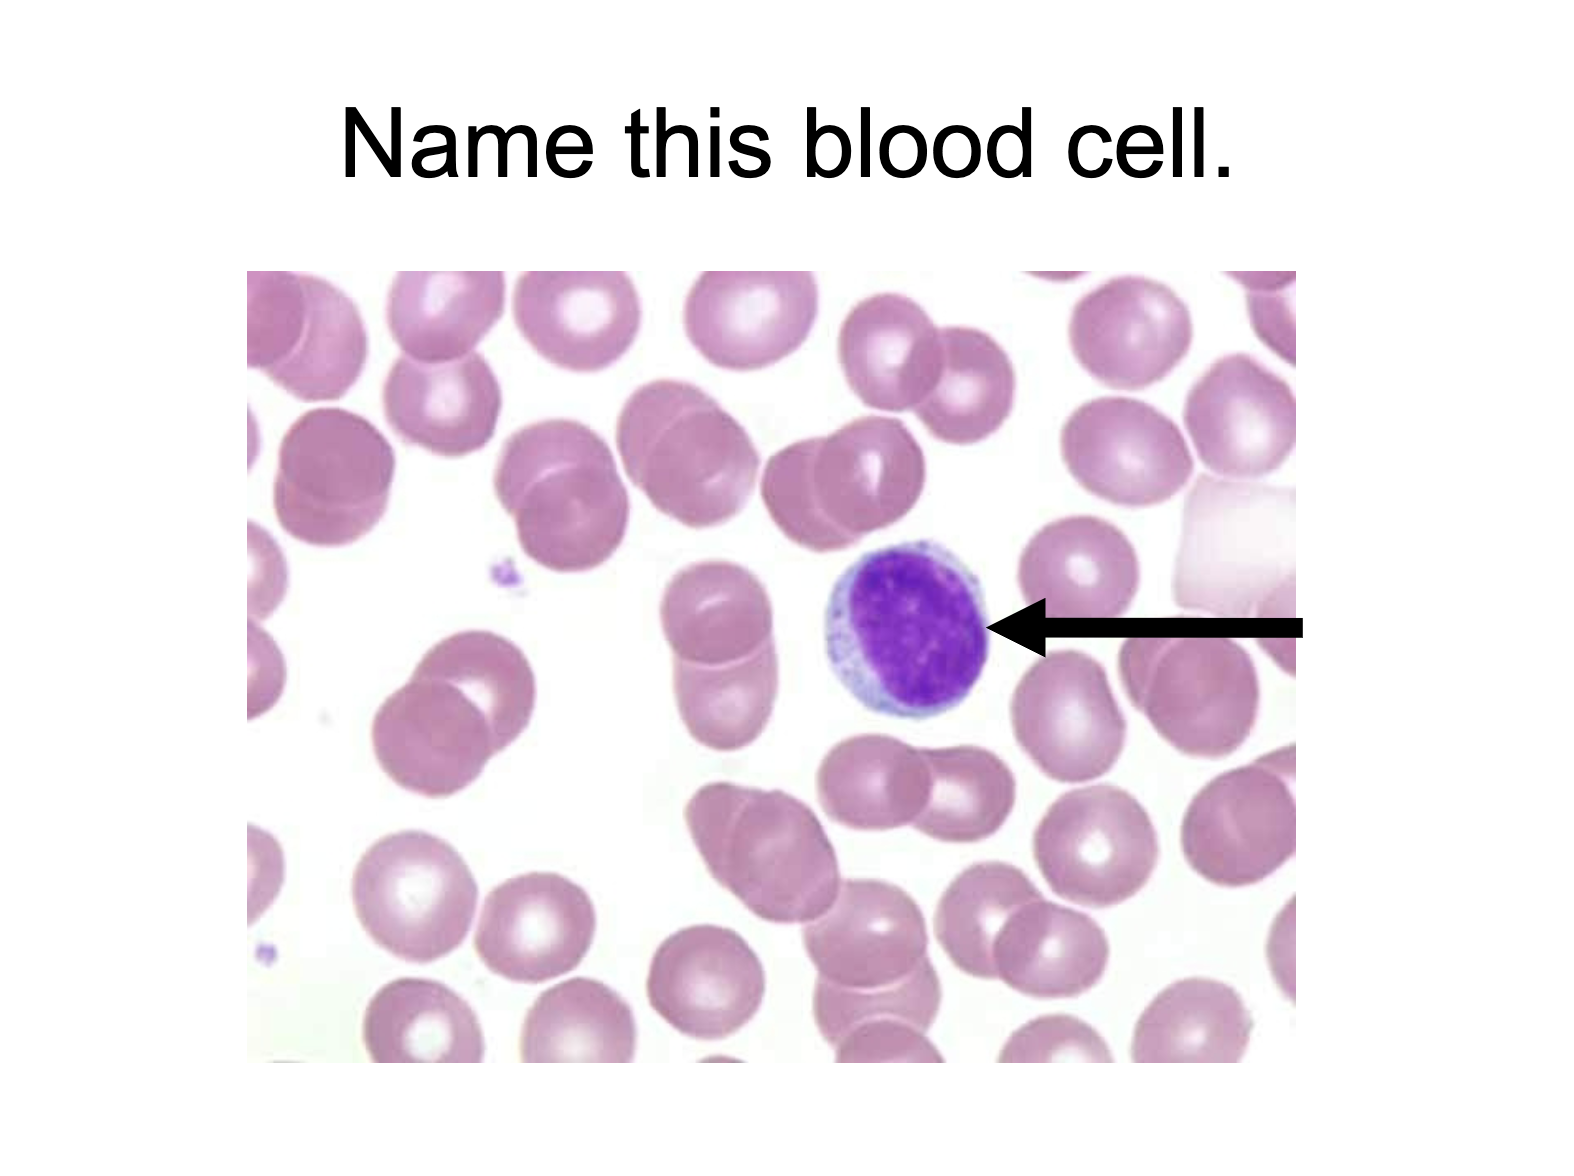
term image
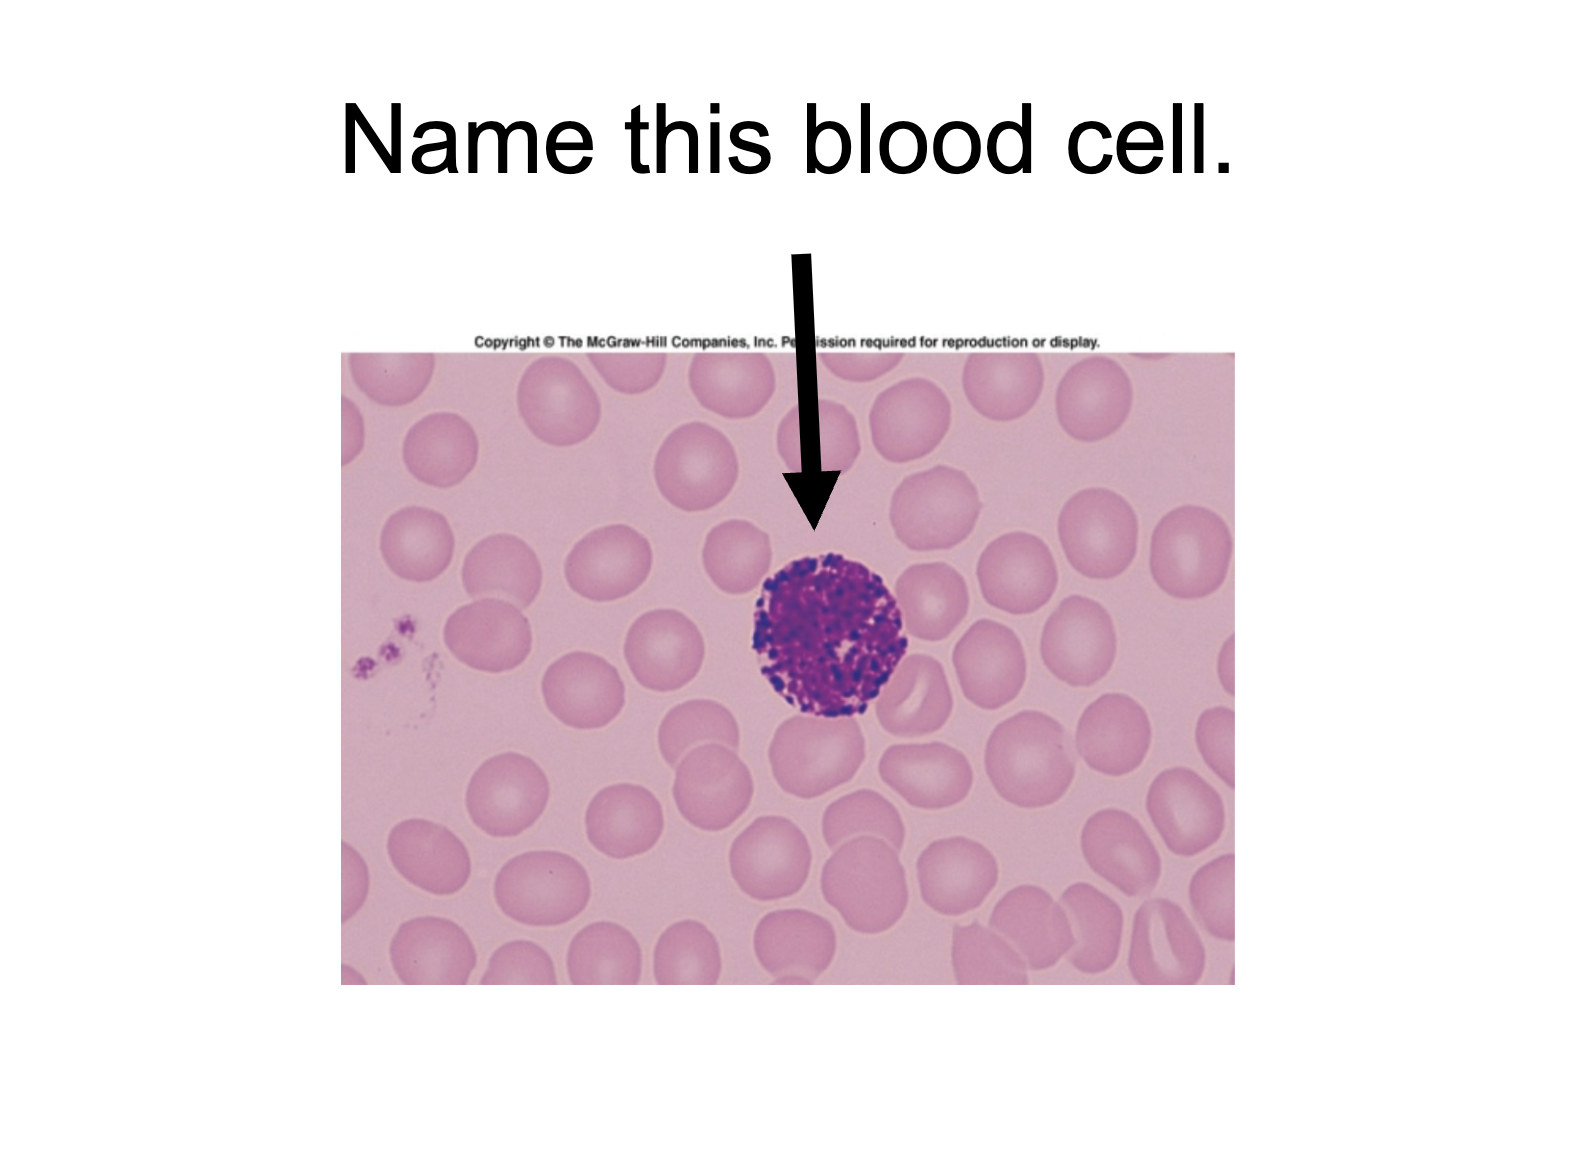
term image
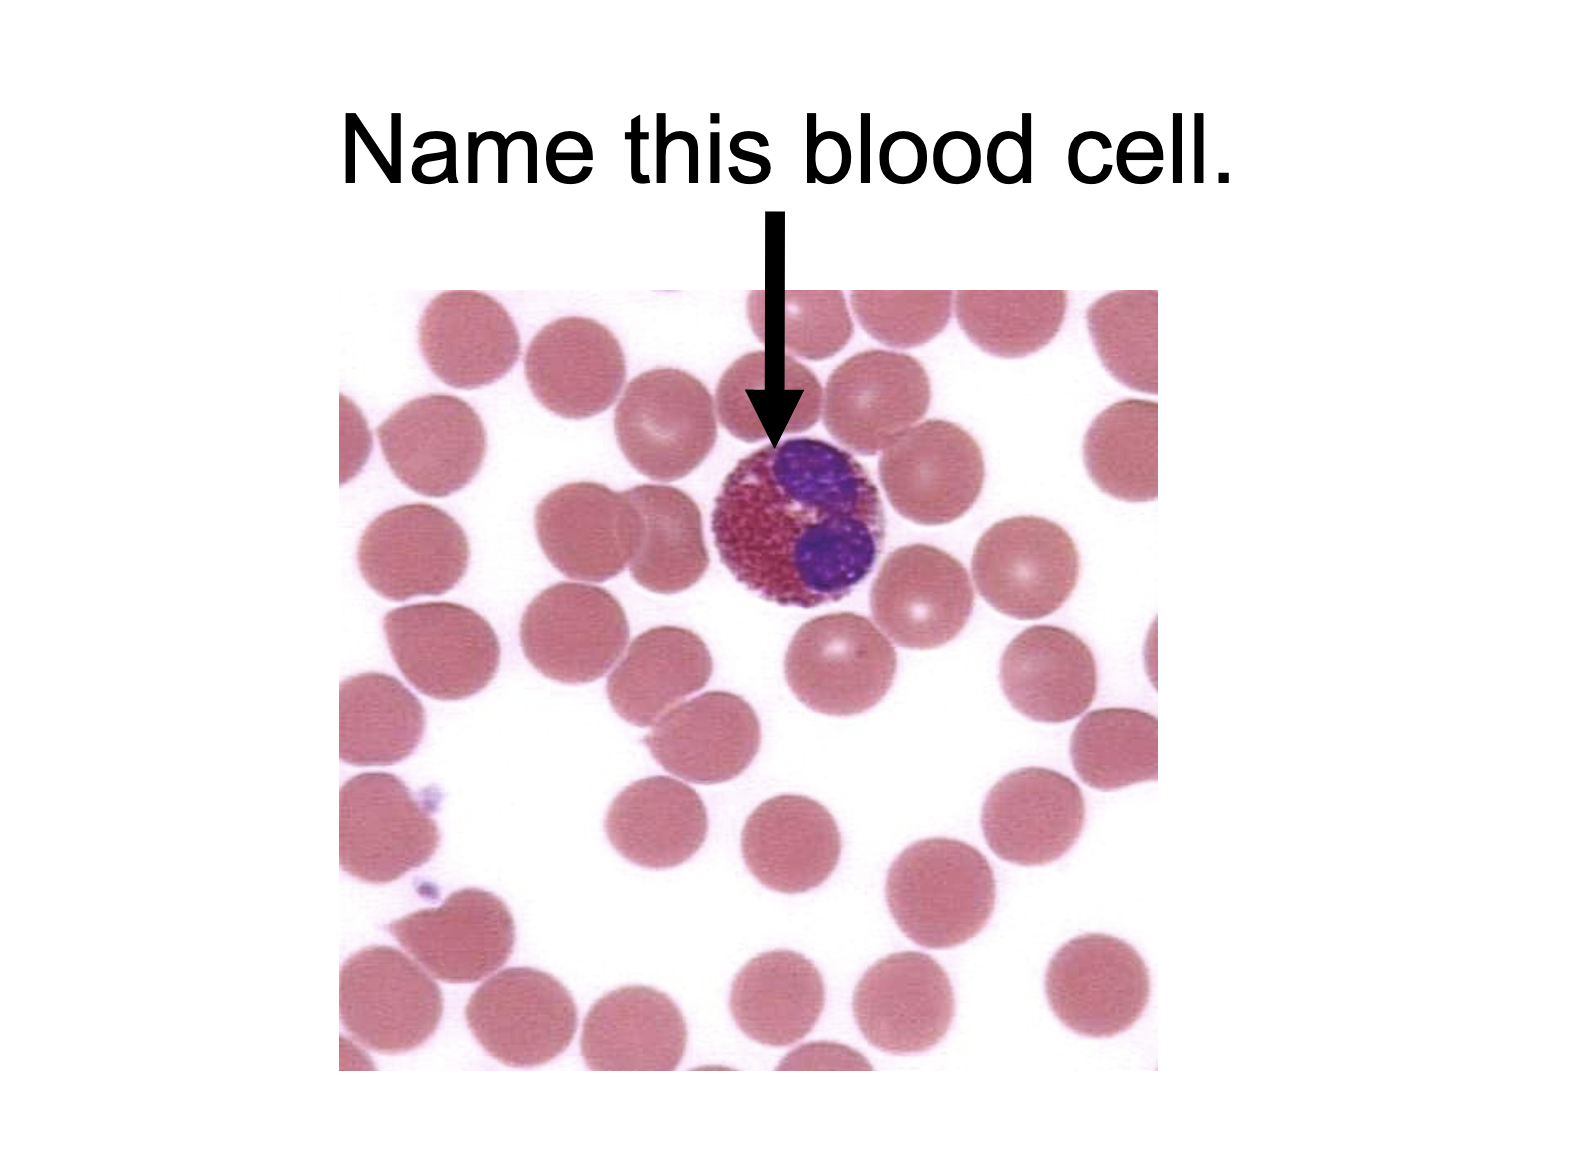
term image

BIOL 210 C - Muscle & Blood Cell Histology
0.0(0)Studied by 0 people
Card Sorting
1/26
There's no tags or description
Looks like no tags are added yet.
Last updated 8:15 PM on 11/7/24
Name | Mastery | Learn | Test | Matching | Spaced | Call with Kai |
|---|
No analytics yet
Send a link to your students to track their progress
27 Terms
1
New cards

skeletal muscle tissue
2
New cards

muscle fiber
3
New cards

perimysium
4
New cards

muscle fascicle
5
New cards

skeletal muscle tissue
6
New cards

muscle fibers
7
New cards

nuclei
8
New cards

striations (A bands and I bands)
9
New cards

motor unit
10
New cards

axons of motor neurons
11
New cards

neuromuscular junctions
12
New cards

cardiac muscle tissue
13
New cards

intercalated discs
14
New cards

nuclei
15
New cards

smooth muscle tissue
16
New cards

nuclei
17
New cards
lymphocyte
18
New cards
basophil
19
New cards
eosinophil
20
New cards

neutrophil
21
New cards

monocyte
22
New cards

#1
vein
23
New cards

#2
tunica externa
24
New cards

#3
tunica media
25
New cards

#4
connective tissue
26
New cards

#5
smooth muscle
27
New cards
tunica intima
simple squamous